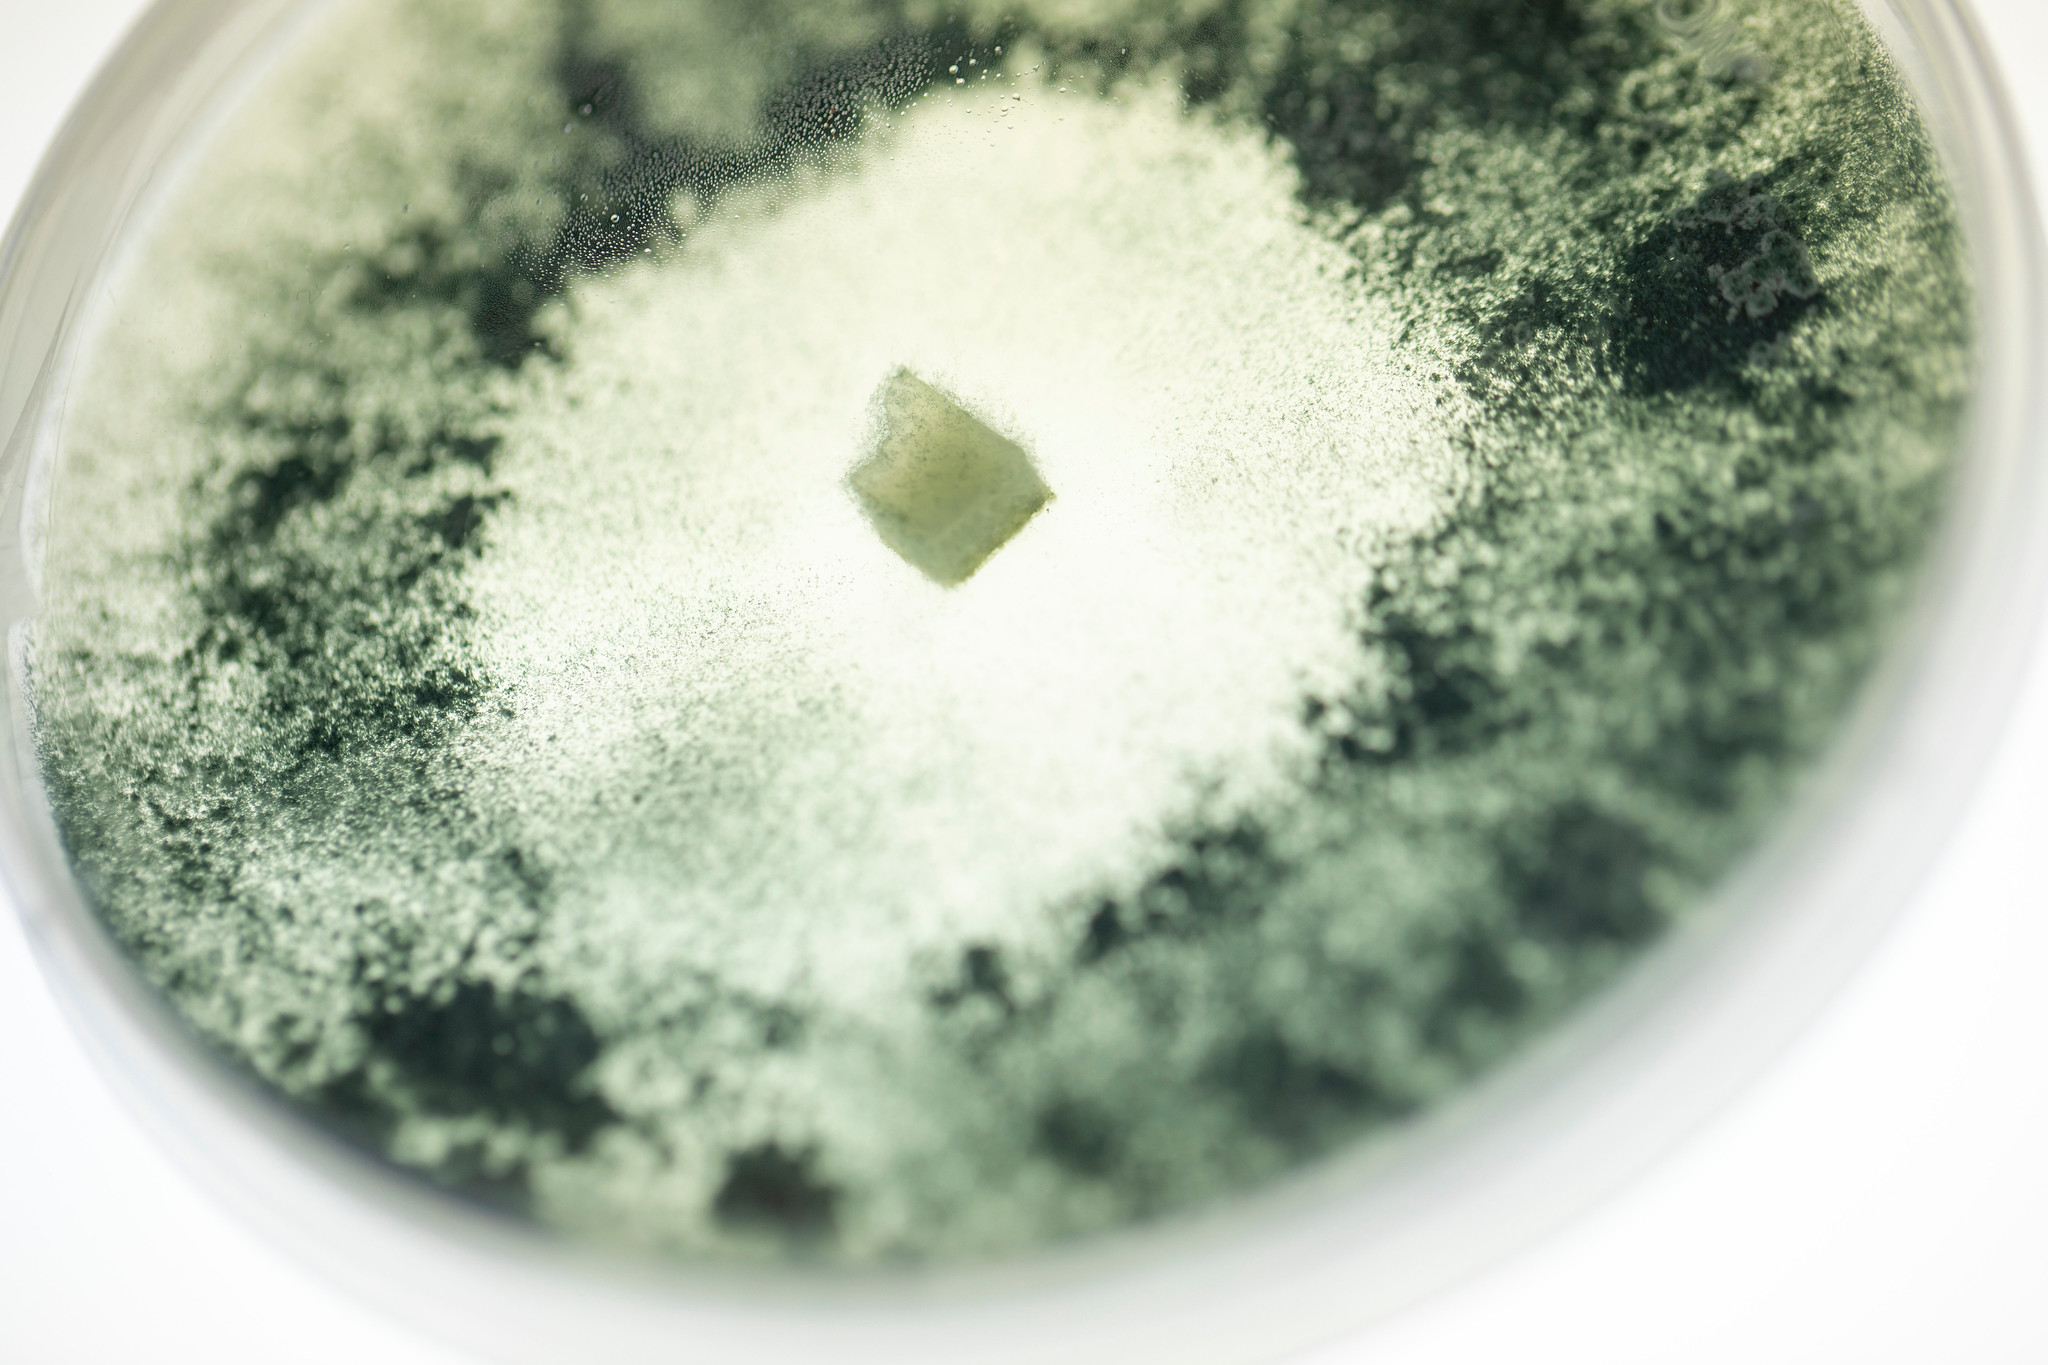

Research at CALS
Guided by the Wisconsin Idea and a land-grant mission, CALS is committed to improving the living world through research that helps people across the state, the nation and the globe.
CALS researchers fuel engine of scientific discovery
The College of Agricultural and Life Sciences (CALS) is committed to improving the living world through research that helps people across Wisconsin, the nation and the globe. Our students, faculty and researchers are making contributions to advance human, animal and plant health; create healthy food systems; and make agriculture more sustainable. To power our engine of scientific discovery, CALS receives funding support from federal and state grants, private donors, industry partnerships and endowments.
Our history as a land grant university
UW–Madison takes its status as a land-grant university seriously. Along with our 111 land-grant peers, our mission is to share knowledge with communities through research and collaboration, a cooperative approach to agricultural research proudly rooted in the founding of our flagship university and the evolution of the Wisconsin Idea.
For every dollar of invested in agricultural research, $20 returns to the American economy
NIH-funded biomedical research supported 407,782 jobs and $94.58 billion in new economic activity nationwide (or $2.56 for every $1 invested)
500 CALS graduate students are funded through federal grants and contracts
How federal funding impacts CALS
CALS researchers are discovering solutions for the complex challenges facing our world. Federal funding supports our ability to innovate solutions to grand societal challenges, such as sustainable agriculture, biodiversity conservation, climate resilience, bioenergy, human health and rural development. These projects are strengthening communities, business and our world, and they are worth fighting for.

UW biochemists engineered a poplar tree that produces a high-demand industrial chemical. It’s a surprise discovery only made possible by sustained research investment.
Over more than three decades, federal agencies, including the Department of Energy, National Institutes of Health and National Science Foundation, have supported his efforts to study that basic biological chemistry — and to engineer changes to organisms that can benefit humanity.

A new tactic in the superbug battle
Vatsan Raman is “supercharging evolution” to create an army of bacteria-killing phages that can combat antibiotic-resistant microorganisms.

UW innovations are helping farmers produce crops with less fertilizer
UW researchers are engineering beneficial, nitrogen-fixing bacteria in crops to improve resiliency and sustainability.

Bovine belch busters
CALS scientists look for ways to reduce methane emissions from cattle with support from the Dairy Innovation Hub and the Green Cattle Initiative.

The Insect Eavesdropper
With low-cost sensors, Emily Bick listens in on insects as they chomp on crops, and she uses what she hears to develop strategies for minimizing damage. It’s federally funded research at risk of being cut.
Global leader in scientific discovery
CALS research centers and collaborators
CALS faculty, staff and students pursue groundbreaking research and partnerships in many places, from on-campus laboratories in academic departments to interdisciplinary, cross-campus complexes, such as the Great Lakes Bioenergy Research Center, the Morgridge Institute for Research and the Wisconsin Institute for Discovery, among others. The college also funds and houses several of its own research centers and institutes where scientists pursue innovations in a wide variety of fields, from dairy to economic policy to plant breeding and more.
Research by the numbers
6
Nobel Prize winners among faculty and alumni
$125.6M
awarded to CALS researchers
in fiscal year 2024
55
patents awarded from July 2022 to July 2025
2,883
peer-reviewed articles published from July 2022 to July 2025
Give to the CALS Fund

With recent changes in the federal funding landscape, our top priority is to ensure our students can remain engaged in their research. Graduate students are the fuel of our research engine, and more than 500 CALS graduate students are funded through grants, contracts and other mechanisms that will be greatly impacted by proposed changes to federal grant funding. It’s critical that the college has flexible funding to support student research opportunities. Gifts to the CALS Fund will support these critical experiences for our undergraduate and graduate students.